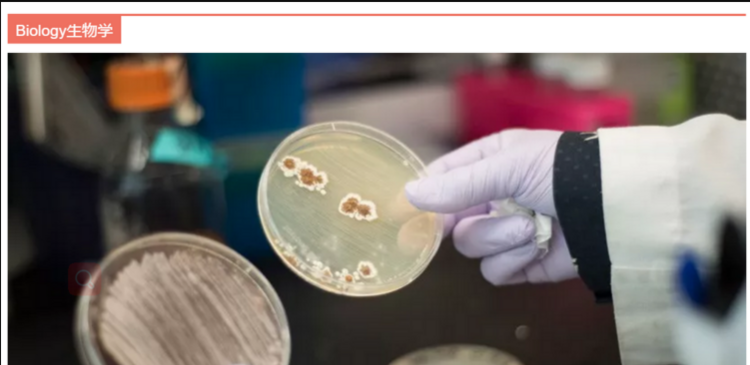
2018加拿大最有吸引力的十大专业（1）

当你觉得那个专业很难申请,离你很远,有时候并不是你不够优秀,而是那个专业其实不适合你。专业排名更多时候是一个参考,找到最适合自己的才是我们的终极目标,这样离你的梦就更进了一步。

正是由于全球留学网老师的专业权威和处处为客户着想的服务理念,迎来了一批又一批口碑客户;以对学生极度负责的工作态度和有口皆碑的客户满意度赢得了过往客户的长久友谊和信赖。全球留学网老师就是这样一位兼具足够专业度和亲和力,并被客户极度信任的行业内专业、优秀的顾问,他数年如一日始终坚守在加拿大留学第一线,专业铸权威,用心常相伴!
如有相关方面意向,请call下面电话联系全球留学网老师,电话与微信同步 ~